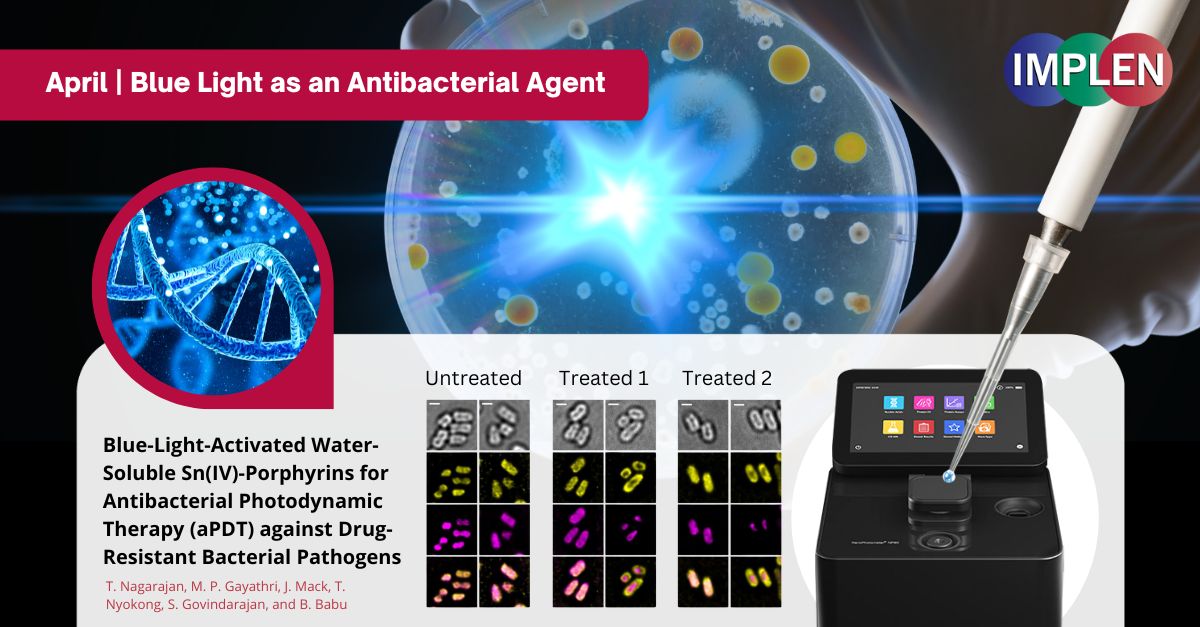

Utilizing KingFisher Technology for Microbial Profiling in Breast Cancer: Unique Signatures in Ethiopian Women
The first issue of the Implen NanoPhotometer® Journal Club is highlighting the study "Human Breast Tissue Microbiota Reveals Unique Microbial Signatures that Correlate with Prognostic Features in Adult Ethiopian Women with Breast Cancer" conducted by Zelalem Desalegn et al., published in the Journal of Cancers, which investigated the microbial profiles in breast tumor and normal adjacent tissues (NAT) in Ethiopian women with breast cancer (BC). This research marks the first comprehensive exploration into the association between microbial dysbiosis and clinicopathological factors in Ethiopian women.
Utilizing fresh frozen breast tumor and normal adjacent tissues (NAT) from the same donors, the study employed advanced molecular techniques, including DNA extraction using the KingFisher robot for high-quality microbial DNA isolation. This automated process ensures integrity and nuclease-free DNA crucial for accurate gene sequencing. This research identified 14 distinct microbiota genera between tumor and NAT tissues. Notably, genera such as Burkholderia correlate strongly with aggressive breast cancer types like triple-negative and basal-like tumors, whereas Alkanindiges, Anoxybacillus, Leifsonia, and Exiguobacterium are associated with HER2-E tumors. Luminal A and B tumors showed weaker microbial correlations. Additionally, a higher abundance of Citrobacter is significantly linked with advanced-stage tumors, underscoring microbial signatures' potential role in breast cancer prognosis among Ethiopian women.
This study's innovative approach, utilizing the KingFisher technology for microbial profiling, paves the way for future microbial-based diagnostic and therapeutic strategies in breast cancer management.
The NanoPhotometer® was used in this work to determine the quality and quantity of nucleic acids.

|

Unlocking New Horizons in Liver Disease Therapy: Milk-Derived Vesicles as Curcumin Carriers
Next, the Implen NanoPhotometer® Journal Club is focusing on groundbreaking research by Albaladejo-García et al., published in the Journal of Biomedicine and Pharmacotherapy. This work demonstrated the therapeutic potential of milk-derived small extracellular vesicles (sEVs) for delivering curcumin, a compound renowned for its antioxidant and anti-inflammatory effects, as a treatment for chronic liver disease.
Despite curcumin's promising health benefits, its practical use is hindered by its poor solubility and poor bioavailability. By utilizing sEVs as a delivery mechanism, this research addressed these limitations, leveraging the vesicles' nanometric scale, non-immunogenicity, and capacity to hold hydrophobic substances. This study revealed that curcumin, when encapsulated in sEVs, showed increased cytotoxicity against tumor cells (RAW264.7 and HepG2) while sparing primary hepatocytes, especially at elevated concentrations, suggesting a targeted toxicity. Furthermore, in-vivo experiments on a liver fibrosis model highlighted the therapeutic advantages of sEVCurAc (curcumin actively encapsulated within sEVs), including a marked decrease in liver damage indicators and fibrogenesis.
This study introduced the use of milk-derived sEVs as a promising platform for curcumin delivery, potentially overcoming the limitations of curcumin's clinical application in liver diseases. This innovative approach could pave the way for developing effective treatments for chronic liver conditions, leveraging the natural properties of sEVs to enhance drug delivery and therapeutic outcomes.
The incorporation of curcumin into the sEV framework was precisely quantified using absorbance measurements with the Implen NanoPhotometer®.

|

Unlocking the Secrets of Drought Resilience: How Sunflower Genotypes Shape Fungal Communities
April showers bring May flowers, but what happens when the rains don't come? This week's Implen NanoPhotometer Journal Club is highlighting the work of Mandel et al., published this year, delves into how drought conditions reshape the fungal communities associated with sunflowers, emphasizing the interplay between different sunflower genotypes and their fungal counterparts.
This research addressed the significant influence of plant-associated microbiomes on traits like disease resistance, nutrient uptake, and stress tolerance. Utilizing a controlled drought experiment involving diverse sunflower lines with varying drought resistances, the study investigated the interaction between watering conditions and sunflower genotypes on rhizospheric (soil surrounding roots) and endospheric (root interior) fungal communities.
The findings of this study revealed that fungal community structures are influenced by several factors including watering treatments, sunflower genotype, and their interactions with the plant compartment. Notably, it was shown that the abundance of plant pathogens and mycorrhizal fungi change with the host's genetic diversity, underscoring the importance of genotype in shaping these microbial communities.
This research contributes to understanding the complex dynamics of plant-fungal interactions under environmental stress, offering insights into developing drought-resilient sunflower varieties. Such knowledge is crucial for enhancing productivity and sustainability in agriculture amid increasing drought incidences, helping breeders and farmers adapt to changing environmental conditions.
The Implen NanoPhotometer® N60 was used in this study to quantify DNA from sunflower rhizosphere and endosphere samples, ensuring consistent DNA concentrations were normalized to 10 ng/μl for downstream PCR and sequencing processes.

|

Revolutionizing Proteomics: Introducing the Heat ‘n Beat Method for Rapid, High-Throughput Sample Processing
The next issue is highlighting the article "Heat ‘n Beat: A Universal High-Throughput End-to-End Proteomics Sample Processing Platform in under an Hour" by Dylan Xavier and colleagues, which presents a significant advancement in the field of proteomics sample preparation. Their work recently published in the journal of analytical chemistry introduced a robust, rapid, and nearly universal protocol for processing small solid tissue samples for mass spectrometry-based proteomic analysis. This new method, referred to as Heat ‘n Beat (HnB), streamlines the preparation process, significantly reducing the time from tissue sample to mass spectrometer loading to under an hour.
Key features of the HnB protocol include a one-tube homogenization and digestion method applicable to various tissue types, irrespective of their preservation methods. The protocol integrates initial washing, tissue disruption, lysis, reduction, alkylation, and proteolysis into a single tube operation, minimizing handling and potential sample loss. This method demonstrates an improved peptide yield, nearly doubling the output compared to previous techniques like the ABLE method, while maintaining high digestion efficiency (85–90%).
HnB's effectiveness was validated across multiple organ types and a large set of human cancer biopsies, showing excellent reproducibility and high-throughput capabilities. For example, 1171 human cancer biopsy samples were processed in 92 hours, yielding consistent peptide quality and quantity across more than 3500 mass spectrometry runs.
This approach is especially beneficial for high-throughput applications, enabling rapid processing of large sample sets within clinically relevant time frames, thus paving the way for advanced proteomic studies with potential clinical applications. The HnB method represents a transformative step in proteomics, providing a streamlined, efficient, and scalable solution for researchers in this rapidly evolving field.
In the "Heat ‘n Beat" proteomics study, the NanoPhotometer® N60 was used to measure the concentration of peptides via UV absorption at 280 nm, ensuring consistent loading onto the mass spectrometer for reliable analysis.

|
Unlocking the Potential of Blue-Light-Activated Sn(IV)-Porphyrins in Combatting Antibiotic-Resistant Bacteria: A Promising Advance in Photodynamic Therapy
The last issue is highlighting a study by Nagarajan et. al. that investigated the effectiveness of blue-light-activated water-soluble Sn(IV)-porphyrins as antibacterial agents for photodynamic therapy (aPDT) against drug-resistant pathogens. These compounds, when excited by a 427 nm LED, were shown to produce reactive oxygen species that effectively killed both Gram-positive and Gram-negative bacteria.
Significant findings of this study included the porphyrins' ability to cause extensive damage to bacterial DNA and membranes, crucial for their potent antibacterial action. This study provided detailed insights into the mechanisms of cell death induced by these porphyrins, emphasizing their potential as alternative treatments to combat antibiotic-resistant bacterial infections. By elucidating the interactions of these porphyrins with bacterial cells, this research paved the way for the development of new photosensitizers with improved aPDT efficacy. This could be particularly beneficial in treating skin infections that are unresponsive to standard antibiotics, offering a promising solution to the escalating problem of antimicrobial resistance.
The Implen NanoPhotometer® NP80 was used in this study to quantify isolated genomic DNA from the E. coli-K12 strain. The NanoPhotometer facilitated accurate dosage calculations of the porphyrins, ensuring that each reaction mixture had a consistent amount of DNA (250 ng per reaction).

|

©2024 Implen. All rights reserved. |